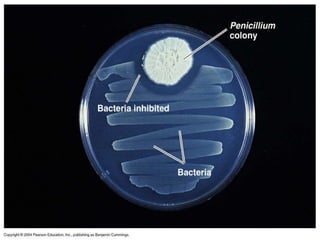
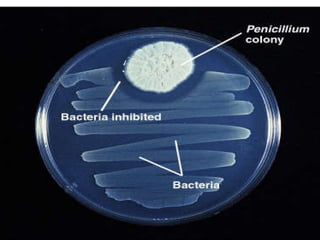
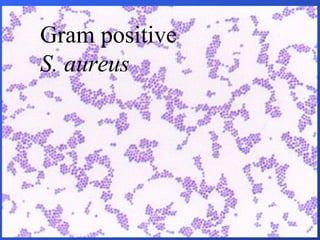
Gram positive S. aureus

- The document discusses the history and scope of microbiology, from early observations of microorganisms in the 1600s to modern discoveries and applications.
- Key figures mentioned include Anton van Leeuwenhoek, who first observed microbes under a microscope, Louis Pasteur who disproved spontaneous generation and established germ theory, and Robert Koch who developed techniques for growing pure cultures of bacteria.
- Microbiology now encompasses the study of bacteria, fungi, viruses, and their roles in medicine, industry, biotechnology, and the environment.